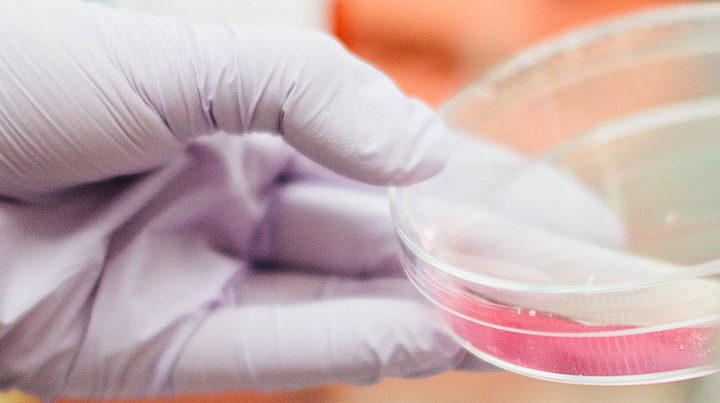
Dummy image

La División de Imágenes, Laboratorios y Patologías es el centro neurálgico del diagnóstico en la Facultad de Medicina UC. Nuestra labor integra la ciencia avanzada con la práctica clínica. Nuestra labor asistencial se potencia con la investigación constante y la formación de los mejores especialistas del país, para proveer diagnósticos oportunos, precisos y humanos, sustentados en la excelencia académica y la innovación científica para mejorar la salud de las personas.
Jefe de División: Dr. Juan Carlos Enrique Roa
Departamentos